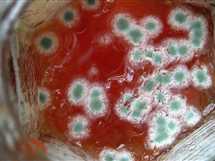

من عفن الطعام إلى السموم.. خطر الميكوتوكسينات في صلصة الطماطم
تلجأ كثير من السيدات إلى إزالة الطبقة السطحية المتعفنة من معجون الطماطم أو المربى ثم استخدام الباقي، ظنًّا أن المشكلة قد انتهت بمجرد التخلص من الجزء الظاهر إلا أن خبراء التغذية يحذرون من خطورة هذا السلوك، مؤكدين أن العفن لا يقتصر على السطح فقط، ولكن قد تمتد جذوره عميقًا داخل الطعام دون أن ترى...
تلجأ كثير من السيدات إلى إزالة الطبقة السطحية المتعفنة من معجون الطماطم أو المربى ثم استخدام الباقي، ظنًّا أن المشكلة قد انتهت بمجرد التخلص من الجزء الظاهر إلا أن خبراء التغذية يحذرون من خطورة هذا السلوك، مؤكدين أن العفن لا يقتصر على السطح فقط، ولكن قد تمتد جذوره عميقًا داخل الطعام دون أن ترى...




























































